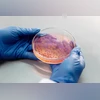
biotech, lab, bacteria biotech, lab, bacteria

Centre to study microbial contamination in ayurvedic, herbal medicines
The decision follows an August 2025 study by the Indian Council of Medical Research, which raised serious concerns about the quality of herbal medicines sold in the market
)
The study assumes significance given that it will improve quality and transparency in the AYUSH sector. Photo: Pexels
Listen to This Article
The Centre has planned a nationwide study to check microbial contamination in herbal materials used in Ayurveda, Yoga, Naturopathy, Unani, Siddha and Homoeopathy (AYUSH) products to improve the safety of traditional medicines.
According to Mint, the Centre is planning a study that will focus on finding bacteria and fungi in herbal ingredients and setting clear microbial limits and testing standards for these materials.
What's the latest?
The decision follows an August 2025 study by the Indian Council of Medical Research (ICMR), which raised serious concerns about the quality of herbal medicines sold in the market. The ICMR’s National Institute of Nutrition found that 63.6 per cent of 110 herbal formulation samples tested had bacterial levels beyond safe limits.
The study found harmful microorganisms such as Staphylococcus, Pseudomonas, E. coli, yeast, and mould, all of which can cause food poisoning, skin infections, and gastrointestinal or respiratory illnesses.
Why it matters?
The study assumes significance given that it will improve quality and transparency in the AYUSH sector, which remains largely unregulated. By setting microbial standards and enforcing stricter testing, the government aims to make traditional medicines safer, more credible, and globally competitive.
Also Read
What the new study will cover?
The upcoming study will test at least 10 widely used herbs in NABL-accredited or AYUSH-approved laboratories. The main focus will be on detecting four dangerous bacteria, such as:
E. coli, Salmonella, Pseudomonas aeruginosa, Staphylococcus aureus
According to the report, the government will also examine the supply chain of herbal materials, identifying points where contamination occurs. Additionally, it will review trade practices and assess how manufacturers maintain quality control while processing and packaging herbal medicines.
Growing industry
India’s herbal and AYUSH products sector is growing rapidly. The domestic market is projected to reach around $200 billion by 2030, up from about $40 billion in 2024, the report said. Exports stood at $689 million in 2024-25, showing the global demand for Indian herbal and traditional medicines.
What do experts say?
Because of this expansion, experts say ensuring product safety is more important than ever. A contamination-related health scare could hurt both consumer trust and India’s export potential in the global wellness market.
According to the report, health experts have welcomed the government’s move, calling it a "necessary alarm" to protect public health. They warn that high microbial loads can be dangerous for older adults or people with weak immunity. Experts also say more studies across different regions are needed to fully understand how widespread the problem is. However, industry representatives have also urged caution, warning against over-regulation.
More From This Section
Don't miss the most important news and views of the day. Get them on our Telegram channel
First Published: Nov 08 2025 | 11:36 AM IST
